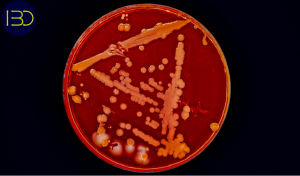

Bagaimana Penyakit dari Hewan Bisa Menular ke Manusia? Memahami Zoonosis dan Konsep One Health
Zoonosis adalah istilah yang digunakan untuk menggambarkan penyakit yang secara alami dapat berpindah dari hewan vertebrata ke manusia. Diperkirakan lebih dari 60 % penyakit infeksi baru pada manusia berasal dari patogen hewan, dan lebih dari 70 % patogen ini memiliki reservoir alami pada satwa liar [1]. Fenomena ini menjadikan zoonosis sebagai tantangan utama dalam kesehatan masyarakat global, terutama dalam konteks perubahan lingkungan, urbanisasi cepat, serta intensifikasi perdagangan satwa dan produk hewan. Istilah zoonosis berasal dari bahasa Yunani zoon yang berarti hewan dan nosos yang berarti penyakit. Sejarah mencatat berbagai wabah besar seperti pes, rabies, dan tuberkulosis sapi sebagai bukti bagaimana patogen hewan dapat menyebabkan kematian massal sebelum sistem kesehatan modern berkembang [3].
Ragam Penyakit Zoonosis, Sumber Hewan, dan Organ Tubuh yang Terdampak
Zoonosis mencakup kelompok penyakit yang luas dengan etiologi, mekanisme penularan, dan organ target yang berbeda. Beberapa zoonosis bakteri, virus, parasit, dan jamur menunjukkan pola klinis serta fisiologis yang unik, tergantung pada sifat patogennya.

- Cysticercosis disebabkan oleh larva cacing pita yang masuk melalui makanan terkontaminasi, berdampak pada sistem saraf dan otot manusia.
- Chagas (Trypanosomiasis) menunjukkan parasit protozoa yang ditularkan oleh Triatomine (kissing bug), menginfeksi jantung dan pencernaan.
- Avian Influenza adalah infeksi virus influenza tipe A yang berasal dari unggas dan menyerang sistem pernapasan.
- Malaria disebabkan oleh protozoa Plasmodium yang ditularkan nyamuk Anopheles dan menyerang sel darah merah serta organ tubuh lainnya.
- Rabies merupakan virus neurotropik yang ditularkan melalui gigitan hewan mamalia dan secara progresif mengganggu sistem saraf pusat.
- Zika adalah arbovirus yang ditularkan nyamuk Aedes aegypti, memengaruhi sistem saraf, termasuk risiko microcephaly pada janin.
Diagram ini membantu memahami bahwa penyakit zoonosis tidak bersifat homogen; masing-masing memiliki jalur biologis penularan dan target organ yang berbeda [2] [4].
Mekanisme Spillover: Dari Hewan ke Manusia
Istilah spillover merujuk pada perpindahan patogen dari hewan reservoir ke manusia. Proses ini biasanya melibatkan serangkaian perubahan evolusioner dan interaksi ekologis yang kompleks.

Secara biologis, spillover bukan sekadar kontak antara manusia dan hewan. Patogen harus mengalami beberapa tahapan kunci:
- Reservoir host maintenance: patogen bertahan lama dalam reservoir (misal virus corona pada kelelawar) tanpa menyebabkan penyakit parah pada hewan tersebut.
- Intermediate hosts: patogen mengalami mutasi atau adaptasi agar mampu menginfeksi inang yang lebih dekat dengan manusia.
- Spillover event: infeksi menyebar ke manusia ketika kontak fisik terjadi — misalnya melalui konsumsi daging, cairan biologis, atau kontak langsung dengan hewan terinfeksi.
- Human-to-human transmission: setelah spillover, banyak patogen kemudian beradaptasi untuk efisiensi penularan antar manusia, seperti pada SARS-CoV-2 [5], [6].
Diagram SARS-CoV-2 menunjukkan bahwa virus yang awalnya beredar di populasi kelelawar berbasis reservoir mutasi, bereplikasi di intermediate host, lalu mampu menginfeksi manusia dan menyebar secara antropogenik.
Rantai Penularan Zoonosis: Kompleksitas Jalur Biologis
Spillover hanyalah satu tahap dari keseluruhan rantai penularan zoonosis. Rantai ini dapat melibatkan berbagai jalur biologis dan interaksi:

Gambar ini merangkum tiga tahap utama:
- Early hosts: patogen awalnya berpindah dari inang primer ke spesies yang rentan. Ini dapat melibatkan hewan domestik atau satwa liar yang menjadi jembatan untuk manusia.
- Spillover to humans: perpindahan ke manusia melalui kontak dekat dengan hewan, konsumsi produk hewani mentah/terkontaminasi, atau paparan lingkungan yang terkontaminasi (air, tanah, udara).
- Human-to-human transmission: setelah infeksi berhasil di tubuh manusia, beberapa zoonosis dapat menular antar manusia melalui droplet, kontak langsung, atau vektor lanjutan, tergantung pada patogennya.
Diagram ini menekankan bahwa interaksi biologis antara patogen dan berbagai inang adalah proses dinamis, bukan linear sederhana [1], [7].
Faktor Ekologi dan Evolusi yang Mempercepat Zoonosis
Biologi epidemiologis zoonosis sangat dipengaruhi oleh faktor lingkungan dan evolusi patogen:
- Perubahan habitat & urbanisasi: mengurangi habitat alami satwa liar sehingga meningkatkan kontak antara manusia dan hewan reservoir.
- Perdagangan hewan/ternak: pergerakan hewan membawa risiko persebaran patogen baru.
- Mutasi antigenik & adaptasi genetik: banyak virus RNA (seperti influenza dan corona) memiliki laju mutasi tinggi yang memungkinkan mereka menembus hambatan spesies baru.
- Perubahan iklim: memperluas jangkauan vektor seperti nyamuk yang memengaruhi distribusi zoonosis berbasis vektor [1], [8].
Secara evolusi, patogen yang mampu “mencapai” sel manusia dengan reseptor yang kompatibel (misalnya ACE2 untuk SARS-CoV-2) memiliki peluang lebih besar untuk berhasil melakukan spillover.
Dampak Klinis pada Tubuh Manusia
Zoonosis menunjukkan spektrum klinis yang luas berdasarkan target organ dan respons imun manusia:
- Sistem saraf pusat: rabies menyebabkan enkesefalitis progresif yang hampir selalu fatal tanpa profilaksis pasca-gigitan.
- Sistem pernapasan: influenza avian, SARS, dan MERS memicu pneumonia berat melalui respons imun inflamasi yang berlebihan.
- Sistem kardiovaskular: Chagas disease menyerang jaringan jantung melalui toksin parasit.
- Sistem pencernaan: cysticercosis menyerang sistem saraf pusat dan otot melalui kista larva cacing pita. Dampak ini mencerminkan bahwa patogen zoonosis dapat memodulasi respon imun berbeda-beda tergantung sel target, virulensi, dan sifat molekuler patogennya [2], [4].
Strategi Pencegahan Berbasis One Health
Karena zoonosis merupakan produk interaksi manusia–hewan–lingkungan, pendekatan One Health adalah strategi yang paling efektif. Pendekatan ini melibatkan kolaborasi lintas disiplin antara dokter, dokter hewan, ahli ekologi, dan pembuat kebijakan:
- Surveilans patogen pada hewan: deteksi dini reservoir dan vektor.
- Biosekuriti peternakan: pengendalian kontak antara hewan domestik dan liar.
- Sanitasi lingkungan: pemutusan rantai penularan melalui sanitasi air, pengolahan limbah, dan pengendalian vektor.
- Edukasi masyarakat: perilaku aman dalam konsumsi produk hewani dan kontak dengan satwa.
One Health membawa paradigma pencegahan zoonosis dari reaktif menuju proaktif [3], [9].
Penutup
Zoonosis adalah konsekuensi biologis dari gangguan ekologis dan adaptasi evolusi patogen yang mampu berpindah spesies. Memahami mekanisme spillover, jalur penularan, faktor ekologis, dampak fisiologis, serta strategi pencegahan lintas sektor adalah kunci dalam upaya global mengurangi risiko penyakit zoonosis di masa depan.
Referensi
- [1] J. P. Messina et al., “The global distribution and burden of dengue,” Nature, vol. 496, pp. 504–507, 2013.
- [2] S. J. Anthony et al., “Global patterns in coronavirus diversity,” Virus Evolution, vol. 3, no. 1, 2017.
- [3] World Health Organization, “One Health,” WHO, 2022.
- [4] P. M. Sharp and B. H. Hahn, “Origins of HIV and the AIDS pandemic,” Cold Spring Harbor Perspectives in Medicine, 2011.
- [5] M. Letko, A. Marzi, and V. Munster, “Functional assessment of cell entry and receptor usage for SARS-CoV-2 and other lineage B betacoronaviruses,” Nature Microbiology, 2020.
- [6] D. E. Gordon et al., “A SARS-CoV-2 protein interaction map,” Nature, 2020.
- [7] D. T. S. Hayman, “Bats as viral reservoirs,” Annual Review of Virology, 2016.
- [8] R. A. Sutherst, “Global change and human vulnerability to vector-borne diseases,” Clinical Microbiology Reviews, 2004.
- [9] C. Mackenzie, N. Jeggo, and S. Daszak, “One Health perspective on zoonotic diseases,” Phil. Trans. R. Soc. B., 2013.